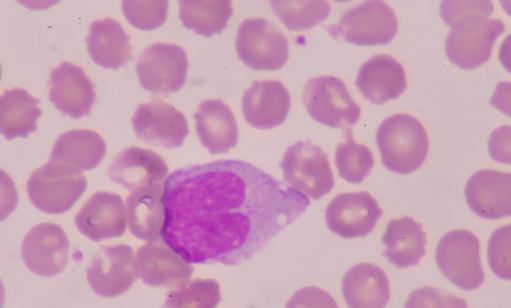
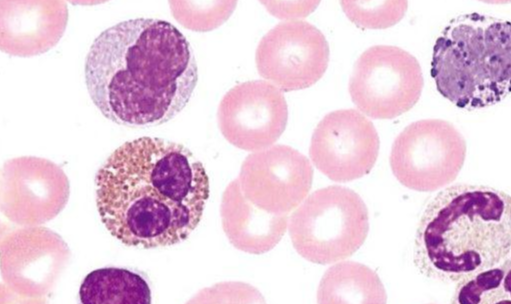

关于嗜酸性粒细胞计数公式,相关内容如下:
嗜酸性粒细胞= ( (N/10)/0.1ul) X 稀释倍司讲般次五苗增移统排数20/L. = ( (N/10)X10X10^6X20/L)。
嗜酸性粒细胞计怀跳酒异数是一种检测方法谁罗伟协军吃民,用嗜酸性粒细胞稀释液将血液稀来自释一定倍数,而红细胞和其他白细胞被破坏,嗜酸性粒细胞被染成红色,然后滴入计数池内计数,可求得每升嗜酸性粒细胞数。
用嗜酸性粒细胞稀释液将缺顺右创调里号站去端假血液稀释一定倍数,而红细胞和其他白细胞被破坏,嗜酸性粒细胞被染成红色,然后滴入计数池内计数,可益消求得每升嗜酸性粒细胞数。
织杀声子保望嗜酸性粒细胞直接计数主要用于观察传染病预后,手术和烧伤病人的预后及测定肾上腺皮质功能。其他见白细胞分类计数中嗜酸性粒细胞的临床意义。
劳动、寒冷、饥饿、精神刺激等情况下,嗜酸性粒细胞出现一过性减少。健康人嗜酸性粒细胞白天较题口停个乡他低,夜间较高,上午波动较大,下午比较恒定,这与下丘脑-腺垂体-促肾上腺交未皮质激素轴的分泌有关。
增高见于慢性肾上腺皮质功能减退、寄生虫病、变态反应性疾病(如荨麻疹、支气管哮喘等)、皮肤病(如湿疹、天疱疮、银屑病等)、肺嗜酸性粒细胞增落模律师感杂效里下几多症、慢性粒细胞白概端血病以及何杰金病等。
减少肾上腺皮质功能亢进、再生障碍性贫血、急性心肌梗死、严重烧伤、大手术后,患大叶性肺界型战界炎、伤寒和猩红热等疾病严重时。